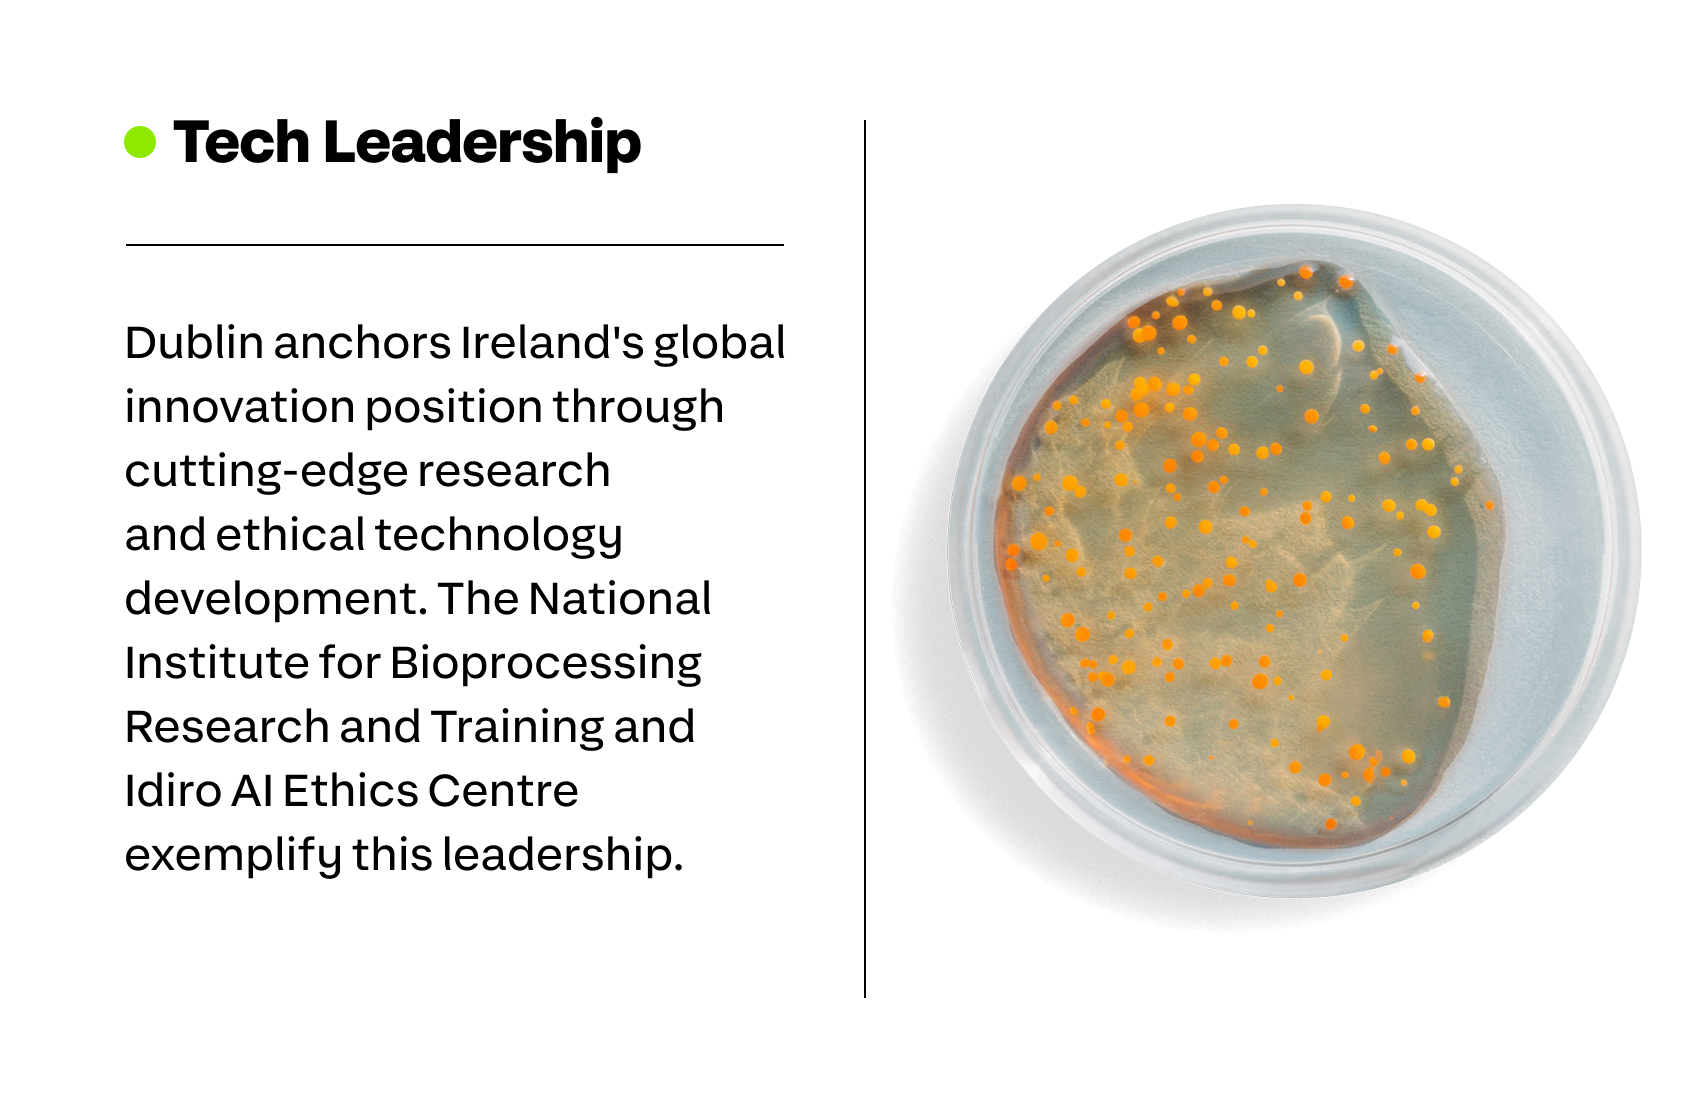

Advanced technology is the new gold. Nearly half of global investors now target AI and advanced tech sectors as their top opportunity, according to Bloomberg FDI data. These technologies drive the resilience and adaptability that define competitive advantage.
While opportunities exist in every region, advanced tech R&D is most likely to flourish in a location with an abundance of skilled workers, strong state support and deep sectoral expertise, and where investment is rewarded. A location like Ireland.
The country has strong momentum in the fields that are unlocking today’s most profound innovations, spanning semiconductors, biotechnology, fintech, AI and the energy transition.
Irish tech is underpinned by the R&D centers of Mastercard, Fidelity Investments, Qualcomm, AMD, Google, Microsoft and other major firms, along with strong university-industry collaboration.
A tour of five Irish tech hubs reveals how the world’s digital future is being redrawn on the Emerald Isle.



Tyndall researchers collaborate globally on breakthrough projects. Their photonics research addresses AI’s data bottlenecks, while bioelectronics programs develop implantable, wearable and injectable health care devices.
Cork is Ireland’s cybersecurity capital, and it has become a magnet for global players in the sector, fueled by skilled graduates from University College Cork and Munster Technological University. In 2024, cybersecurity leader Proofpoint announced Cork as the site of its new international hub, creating 250 jobs.
Many of the world’s largest biopharma companies are active in County Cork, including Pfizer, MSD, AbbVie, Merck, Gilead and Johnson & Johnson. They are pushing the boundaries of sustainability as well as science: Eli Lilly’s onsite solar project, for example, reduces its carbon footprint by the equivalent of 5,000 acres of forest.
Motorola Solutions is investing in a new R&D center in Cork that will design software for its land mobile radio (LMR) portfolio. And employee communications platform Workvivo, founded in Cork before its acquisition by Zoom, is establishing a flagship hub, bringing 100 research and innovation jobs.
Some of the world’s most innovative chip design solutions also emerge from Cork, which is a core IT and engineering hub for Qualcomm. A team of over 650 people work at the company’s base, which includes an integrated circuit design center of excellence.



Medtronic headquarters in Galway serves as a center of excellence for operations and R&D, supporting the company’s global cardiac and vascular businesses. The company employs 4,000 people across its five Irish sites.
Nearby, Boston Scientific carries out advanced product design, R&D and manufacturing, and exports over 4 million medical devices from the city each year. Its most recent expansion includes over 40,000 square feet of manufacturing space that will be powered by renewable energy.
Orthopedic innovator Zimmer Biomet is another company modeling sustainable growth. It generates almost 8% of its annual energy needs from solar panels installed on the roofs of both its Galway and Shannon sites.
Among the most recent medtech arrivals is Dexcom, a maker of glucose monitoring products. The company selected Athenry, 25 km from Galway’s city center, as the site of its first European facility, which will create over 1,000 jobs in the coming years.
Health care is not Galway’s only specialty. Leading global chip company Arm recently opened its new state-of-the-art facility there—a vote of confidence not just for Galway, but also for Ireland’s National Semiconductor Strategy, which aims to put the country at the forefront of the sector.
Alongside pure-play tech companies, Galway’s leading businesses include financial services firms such as Fidelity Investments, whose operations there focus on software development.



The Limerick site of global semiconductor manufacturer Analog Devices hosts its European research and development center, as well as Catalyst, the company’s innovation and collaboration hub, where customers, partners and Irish SMEs collaborate to solve industrial challenges.
Established in 2005, Johnson & Johnson’s Limerick base is a state-of-the-art manufacturing and R&D site that produces critical medicines for immunology and for oncology patients. The group has invested €900 million to develop manufacturing capabilities there.
Life-changing treatments will also be developed in Raheen, a Limerick suburb, where Eli Lilly is putting the finishing touches on its $1 billion plant. It will operate as a fully digital site, incorporating advanced automation to increase production and develop new products, while using 35% less energy than traditional plants.
In fintech, North (formerly known as North American Bancard) recently chose Limerick for its new R&D center. It joins around 140 international companies and some 300 domestic firms working in the fintech sector across Ireland, together employing 7,000 people.



In recent years, Intel’s Leixlip operation has taken on a new dimension with its €17 billion Fab 34 plant—Ireland’s biggest-ever construction project—where Intel deploys extreme ultraviolet lithography in high-volume manufacturing, a first for mass production in Europe. This has ushered in the company’s Meteor Lake processors, and introduced AI PCs to the mainstream.
Intel Ireland is at the forefront of the company’s global sustainability efforts, with more than €67 million invested in energy and water conservation projects at Leixlip in recent years.
Leixlip also has a strong association with Hewlett-Packard, which was Ireland’s largest IT employer until its restructuring in 2015. Today, its successor company, HPE, continues to grow across sites in Kildare and Galway, which are R&D hubs for the company’s GreenLake hybrid cloud portfolio.

The equally charming and historic town of Newbridge is another focus of business investment. Pfizer’s 1-million-square-foot facility there is one of Europe’s largest sites manufacturing solid dose pharmaceuticals, and one of the group’s five sites across Ireland.
Newbridge is also home to Keurig Dr Pepper’s ambitious sustainability transformation. The company is investing €6.44 million to electrify its beverage concentrate facility through advanced heat pump technology. Once complete, the production facility will operate on 100% renewable electricity and reduce carbon emissions by approximately 1,600 metric tons annually, supporting KDP’s 2030 climate commitments while manufacturing concentrates for global brands including Dr Pepper, Canada Dry and 7UP.

Google established its European HQ in Dublin in 2004, placing Ireland firmly on the tech map. Today, it sits alongside other global tech titans and domestic startups that continuously innovate and keep the city’s business ecosystem at the cutting edge.
AI has the potential to boost Ireland’s economy by up to €45 billion within a decade, according to research commissioned by Google. The company is helping to realize this potential through multiple initiatives. For example, its partnership with CeADAR, Ireland’s European digital hub for AI, aims to support Irish businesses scaling AI capabilities.

Meanwhile, Microsoft is filling the AI skills gap with a national skilling program. With a history in Ireland dating from 1985, the company continues to invest there, and recently announced 550 new job roles to pioneer AI technologies. The boost will push Microsoft’s Irish headcount above 6,000 people, who work at its campus in the Dublin suburb of Leopardstown and its data center campus in Kildare.
Mastercard is another large and growing Dublin employer. Its European tech hub opened in Dublin in 2022 and is expected to house over 2,000 people this year, combining expertise in payments security, APIs and emerging technologies.
Dublin is also a longstanding flagship European R&D site for semiconductor giant AMD. In 2024, the firm signaled continued growth in Ireland through an investment of up to $135 million over four years to fund strategic R&D projects.

Ireland’s tech specialties are clustered in hubs that span the island. Its modern infrastructure and close connections—Galway and Dublin, on opposite coasts, are less than three hours apart—foster collaborative ecosystems.
Together, these capabilities position Ireland as more than just a tech hub. The country is an incubator-in-chief for the next wave of transformative technologies—ready to power Europe’s digital and green transitions.